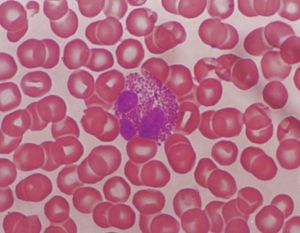
嗜酸粒細胞性胃腸炎 嗜酸粒細胞性胃腸炎

病因
病因尚不清楚,可能與食物過敏有關,兒童多見,成人很少能找到與過敏有關的食物,有藥物或毒素引起本病的報告。
臨床表現
嗜酸粒細胞性胃腸炎病變主要侵犯胃腸黏膜組織,常見症狀有噁心、嘔吐、腹痛、腹瀉、體重下降和腰背痛,進食特殊過敏食物可使症狀加重。體檢可發現皮膚濕疹、蕁麻疹、足踝部水腫等。部分患者還可因胃腸道出血表現為貧血。病變廣泛時出現小腸吸收不良、蛋白丟失性腸病、貧血等全身性表現,青少年出現發育不良,生長遲緩,女性可有繼發性閉經。
2.肌層型(Ⅱ型)
以肌層病變為主,由於本型胃和小腸壁增厚、僵硬,臨床主要表現為完全性或不完全性幽門和小腸梗阻、噁心、嘔吐、腹痛,抗酸藥或抗膽鹼藥難以緩解。
3.漿膜型(Ⅲ型)
漿膜下層病變為主,相對少見,占整個嗜酸細胞性胃腸炎的10%左右。可出現腹腔積液,腹腔積液中含大量的嗜酸性細胞,本型可單獨存在,亦可與其他兩型並存。
檢查
1.血液檢查
80%的病人有外周血嗜酸性粒細胞增多,黏膜和黏膜下層病變和肌層病變為主的病人(1~2)×109/L,漿細胞病變為主時,可達8×109/L。還可有缺鐵性貧血,血清白蛋白降低,血IgE增高,血沉增快。
2.糞便檢查
嗜酸細胞性胃腸炎糞便檢查的意義是除外腸道寄生蟲感染,有的可見到夏科-雷登結晶,便常規檢查潛血呈陽性,有些病人有輕中度脂肪瀉。Cr標記白蛋白增加,α-抗胰蛋白酶清除率增加,D-木糖吸收試驗異常。
3.X線檢查
嗜酸細胞性胃腸炎缺乏特異性,X線鋇餐可見黏膜水腫,皺襞增寬,呈結節樣充盈缺損,胃腸壁增厚,腔狹窄及梗阻。
4.CT檢查
可發現胃腸壁增厚,腸系膜淋巴結腫大或腹腔積液。
5.內鏡及活檢
適用於黏膜和黏膜下層病變為主的嗜酸細胞性胃腸炎。鏡下可見黏膜皺襞粗大、充血、水腫、潰瘍或結節,活檢從病理上證實有大量嗜酸粒細胞浸潤,對確診有價值。但活檢組織對於肌層和漿膜層受累為主的病人價值不大,有時需經手術病理證實。
5.腹腔穿刺
腹腔積液病人必須行診斷性腹腔穿刺,腹腔積液為滲出性,內含大量嗜酸性粒細胞,必須做腹腔積液塗片染色,以區別嗜酸性粒細胞和中性粒細胞。
6.腹腔鏡檢查
腹腔鏡下缺乏特異性表現,輕者僅有腹膜充血,重者可類似於腹膜轉移癌。腹腔鏡檢查的意義在於進行腹腔黏膜組織活檢,得到病理診斷。
7.手術探查
對於懷疑嗜酸細胞性胃腸炎一般不行剖腹探查術來證實,但當有腸梗阻或幽門梗阻或懷疑腫瘤時才進行手術。
診斷
主要根據臨床表現、血象、放射學和內鏡加病理檢查結果進行診斷。
1.Talley標準
①存在胃腸道症狀。②活檢病理顯示從食管到結腸的胃腸道有1個或1個以上部位的嗜酸性粒細胞浸潤,或有放射學結腸異常伴周圍嗜酸性粒細胞增多。③除外寄生蟲感染和胃腸道以外嗜酸性粒細胞增多的疾病,如結締組織病、嗜酸性粒細胞增多症、克羅恩病、淋巴瘤等。
2.Leinbach標準
①進食特殊食物後出現胃腸道症狀和體徵。②外周血嗜酸性粒細胞增多。③組織學證明胃腸道有嗜酸性粒細胞增多或浸潤。
鑑別診斷
1.對於以消化不良為表現的病人要與消化性潰瘍、反流性食管炎、胃癌、慢性胰炎等鑑別。
2.肌層型常可發生腸梗阻,要注意除外胃腸腫瘤和腸道血管性疾病等。
3.嗜酸性粒細胞增多症是一種病因未明的全身性疾病,它也可累及胃腸道。60%累及肝臟、14%累及胃腸道,瀰漫性嗜酸粒細胞性胃腸炎除胃腸道外,常有50%累及胃腸道外的器官。
4.腸道寄生蟲感染可引起各種非特異性消化道系統症狀,同時出現外周血嗜酸性粒細胞增多。反覆檢查糞便蟲卵可以鑑別。
5.支氣管哮喘、過敏性鼻炎、蕁麻疹,除可有外周血嗜酸性粒細胞增高外,各有其臨床表現。
6.嗜酸性肉芽腫主要發生在胃、大小腸,呈局限性包塊,外周血嗜酸性粒細胞一般不升高,病理學特點為嗜酸性肉芽腫混於結締組織基質中。
7.如變態反應性肉芽腫病(Churg-Strauss綜合徵)和結節性多動脈炎,其他結締組織病如硬皮病、皮肌炎和多發性肌炎可累及胃腸道,出現腹痛、消化不良等症狀,可出現不同程度的外周血嗜酸性粒細胞增多。小腸黏膜活檢有助於鑑別診斷。
併發症
青少年期發病可導致生長發育遲緩,並可有閉經。以肌層受累為主時的典型臨床表現為腸梗阻或幽門梗阻,出現相應的症狀和體徵。偶爾嗜酸性粒細胞浸潤食管肌層,引起賁門失弛緩症。以漿膜層受累為主最少見,典型表現為腹腔積液,腹腔積液中可見大量嗜酸性粒細胞。
治療
1.一般治療
對於確定或可疑的食物、藥物應停止服用,有些特異性食物牛奶、蛋類、肉類魚蝦等,控制進食後症狀可減輕。
2.藥物治療
糖皮質類固醇激素治療有良好的療效,潑尼松,服藥後1~2周症狀控制後可減量維持,逐漸停藥。色甘酸鈉能抑制肥大細胞脫顆粒,防止組胺的釋放,療程6周至數月不等,適於激素治療無效者。
3.手術治療
當出現幽門梗阻和腸梗阻時,內科保守治療無效者,可採取手術治療,術後易復發,術後需用激素維持治療。
預後
本病預後良好,無惡變的報告。